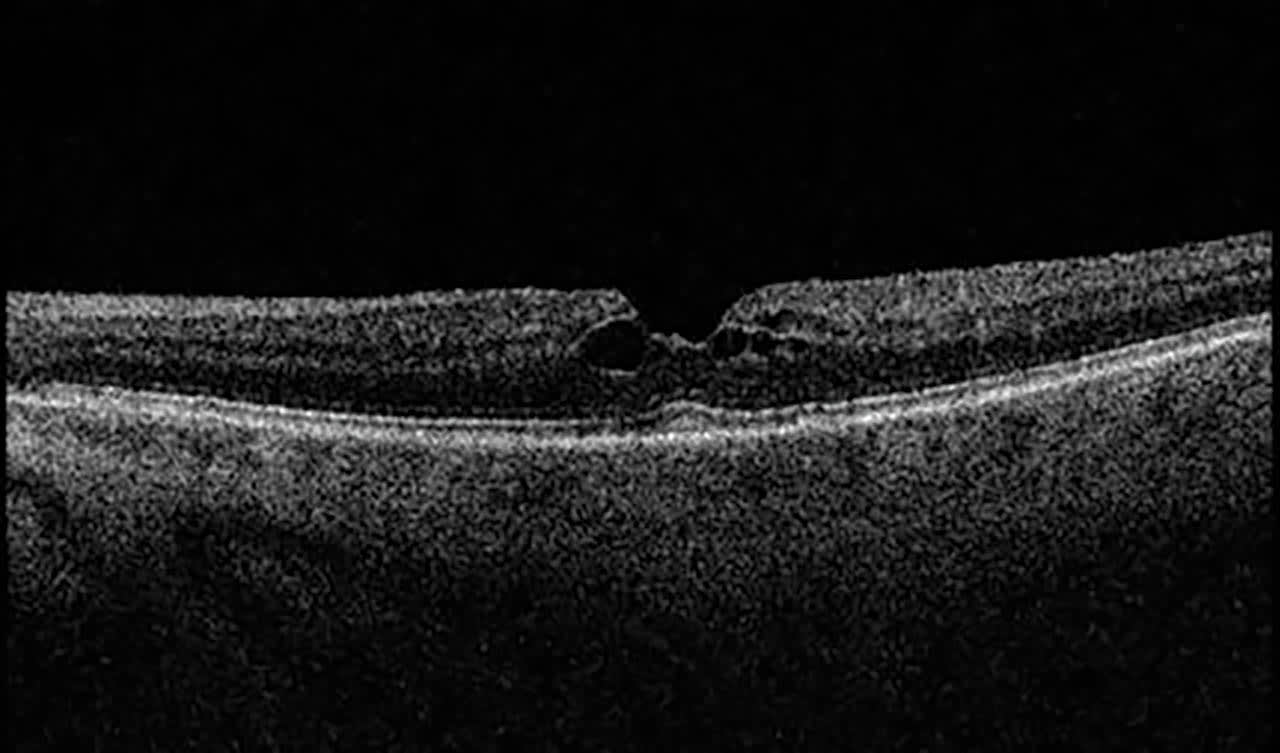
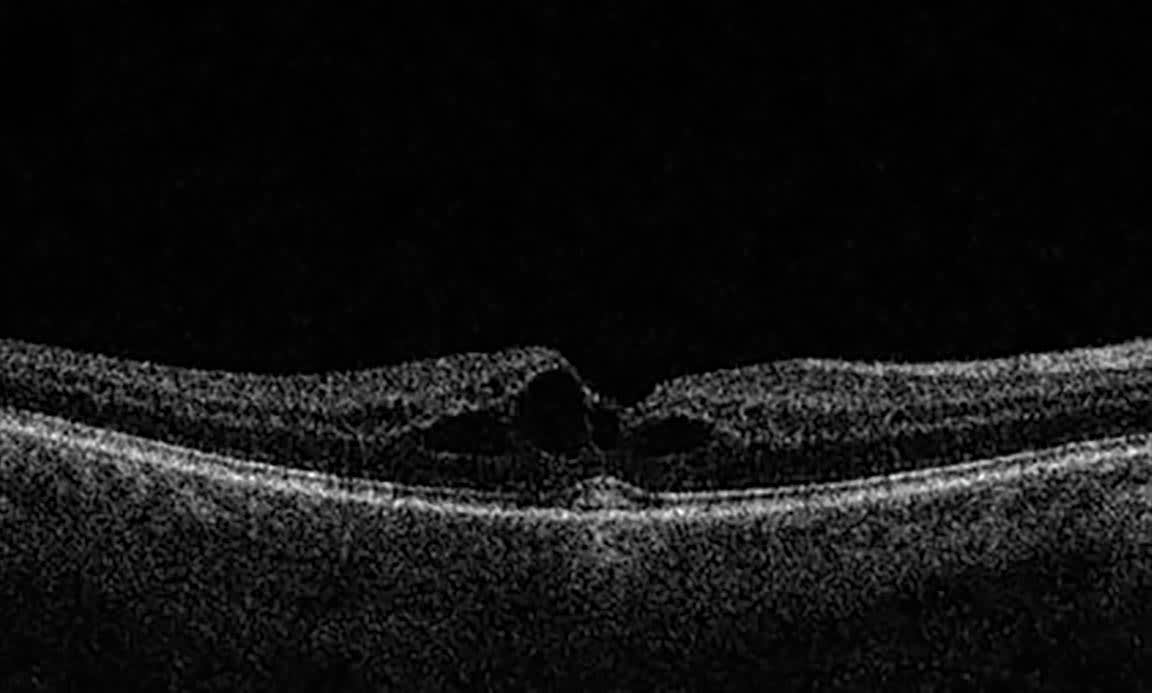

Ozanimod (Zeposia; Bristol Myers Squibb), a selective sphingosine-1-phosphate (S1P) receptor modulator, is used for induction and maintenance therapy of patients with relapsing multiple sclerosis and moderate to severe ulcerative colitis. Binding of the S1P receptor leads to internalization and prevents lymphocyte mobilization to inflammatory sites. This oral medication has recently been introduced in the United States; it was approved in 2020 for relapsing multiple sclerosis1 and in 2021 for moderate to severe ulcerative colitis.2 The dosages of ozanimod for relapsing multiple sclerosis and moderate to severe ulcerative colitis are similar: Induction dosage of 0.23 mg once daily on days 1-4, then 0.46 mg once daily on days 5-7, followed by a maintenance dose of 0.92 mg once daily starting on day 8.1,2
The most common adverse effects of ozanimod include infection (10% to 35%), increased liver enzymes (5% to 11%), headache (4%-5%), hypertension (1%-4%), lymphocytopenia (2%-3%), and fever (3%). One of the less common adverse effects is macular edema. In the phase 3 trial of ozanimod for moderate to severe ulcerative colitis, macular edema occurred in 3 out of 1,026 patients treated with ozanimod (0.29%). Two patients were observed to have macular edema in the induction period (0.25%) and 1 patient during the maintenance period (0.43%). Results in the phase 3 trial state that all 3 cases of macular edema resolved after ozanimod discontinuation.3 Other S1P receptor modulators have also shown a similar adverse ocular effect of CME, such as fingolimod4 and ponesimod.5

Figure 1. In a patient receiving ozanimod, initial optical coherence tomography (OCT) macula scans of the left (top) and right (bottom) eyes reveal cystic fluid accumulation in the outer plexiform layer of the retina, suggesting cystoid macular edema. Images courtesy Jeffrey Bloom, DO.
Cystoid macular edema (CME) has been known to occur with several pathologic conditions. Some of these include intraocular inflammation secondary to uveitic or infectious origin, diabetes, or retinal vein occlusion. CME can also occur after intraocular surgery or with the use of certain agents, including nicotinic acid, topical prostaglandin analogs (latanoprost), antimicrotubular agents (paclitaxel, docetaxel), and trastuzumab, to name a few.6 CME occurs from disruption of the blood-retinal barrier resulting in leakage from retinal capillaries. This leakage leads to serous fluid accumulation in the outer plexiform layer of the central macula. Symptoms typically include metamorphopsia, micropsia, central scotoma, and varying ranges of visual acuity as poor as 20/400.7
To our knowledge, there has been 1 report of CME after induction of ozanimod for moderate to severe ulcerative colitis, but no case reports of CME associated with use of maintenance dose.8 Our case report will discuss asymptomatic CME in the maintenance period of ozanimod use for moderate to severe ulcerative colitis.
Case Report
An 81-year-old woman with a history of ulcerative colitis, hyperlipidemia, and hypertension presents for routine annual ophthalmologic evaluation. The patient denies any worsening blurry vision in either eye; however, she notes mild glare with night driving. Otherwise, she denies any ocular complaints. She denies any history of diabetes or uveitis. Her ocular history includes blepharitis and cataracts in both eyes. The patient inquired about ocular effects of a medication that she has been taking for the past 4 months, ozanimod, which she takes for ulcerative colitis prescribed by her gastrointestinal specialist.
On examination, she was 20/30 OD and 20/40 OS, no improvement with pinhole and unchanged from baseline. Examination of the ocular adnexa and anterior segment showed dermatochalasis and combined nuclear sclerotic and cortical cataracts OU. Posterior segment examination showed a single large drusen in the macula OD; otherwise, findings were relatively unremarkable.
Upon further review of ocular side effects of ozanimod given the patient’s concerns, an optical coherence tomography (OCT) scan of the macula was performed in both eyes. OCT of the macula showed cystoid macular edema in both eyes as shown in Figure 1. The patient was started on prednisolone acetate 1% and ketorolac 0.5% drops 4 times daily OU. The patient’s gastrointestinal specialist was contacted to discuss discontinuing the ozanimod and finding a suitable alternative.
One month later, the patient returned for repeat OCT-macula testing which showed improved macular edema OU. She noted that she discontinued ozanimod and switched to vedolizumab (Entyvio; Takeda Pharmaceuticals) after discussing this with her gastrointestinal specialist. Her prednisolone acetate and ketorolac were tapered to 3 times daily OU for another month, then 2 times daily and daily for subsequent months, then the medication was discontinued. After the second month of treatment, CME was fully resolved (Figure 2). At the conclusion of the tapered drop regimen, CME remained absent.


Figure 2. Optical coherence tomography macula scans of the left (top) and right (bottom) eyes 2 months after treatment reveal resolution of cystic fluid accumulation in the outer plexiform layer of the retina. Images courtesy Jeffrey Bloom, DO.
Discussion
To our knowledge, this is the first case report describing asymptomatic cystoid macular edema associated with maintenance dose of ozanimod. Our patient was placed on ozanimod 4 months prior to her initial ophthalmic exam under our care when CME was observed. With no obvious timeline of visual complaints, it is likely that the CME was of insidious onset. Discontinuation of ozanimod with medical management of prednisolone acetate and ketorolac successfully resolved the CME. Patient’s CME has remained absent after taper completed. We plan to follow her for annual ophthalmic exams with strict return to clinic precautions if any new visual symptoms arise.
With this case report, we have reiterated the adverse effect of CME while on maintenance dose ozanimod and, more importantly, in an asymptomatic patient. This case report also reiterates the adverse effect profile of S1P receptor modulators. Further research is needed to evaluate the percentage of patients that experience asymptomatic CME while taking ozanimod or other medications in this class. If this percentage is significant, a screening recommendation may be needed for this class of medications. NRP
References
1. Lamb YN. Ozanimod: first approval. Drugs. 2020;80(8):841-848. doi:10.1007/s40265-020-01319-7
2. Paik J. Ozanimod: a review in ulcerative colitis. Drugs. 2022;82(12):1303-1313. doi:10.1007/s40265-022-01762-8
3. Sandborn WJ, Feagan BG, D’Haens G, et al. Ozanimod as induction and maintenance therapy for ulcerative colitis. N Engl J Med. 2021;385(14):1280-1291. doi:10.1056/NEJMoa2033617
4. Jain N, Bhatti MT. Fingolimod-associated macular edema: incidence, detection, and management. Neurology. 2012;78(9):672-680. doi:10.1212/WNL.0b013e318248deea
5. Olsson T, Boster A, Fernández Ó, et al. Oral ponesimod in relapsing-remitting multiple sclerosis: a randomised phase 2 trial. J Neurol Neurosurg Psychiatry. 2014;85(11):1198-1208. doi:10.1136/jnnp-2013-307282
6. Rotsos TG, Moschos MM. Cystoid macular edema. Clin Ophthalmol. 2008;2(4):919-930. doi:10.2147/opth.s4033
7. Bringmann A, Reichenbach A, Wiedemann P. Pathomechanisms of cystoid macular edema. Ophthalmic Res. 2004;36(5):241-249. doi:10.1159/000081203
8. Wei L, Patil SA, Cross RK, Taubenslag KJ, Schocket LS. Cystoid macular edema after initiation of ozanimod for ulcerative colitis. Am J Gastroenterol. 2024;119(3):413. doi:10.14309/ajg.0000000000002622












